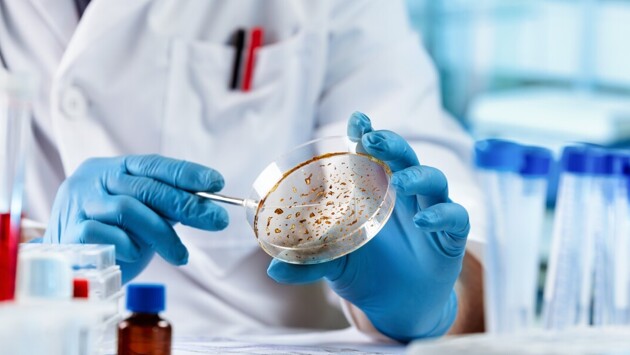

Новый вирус болотистых мест описали китайские ученые
Китайские ученые описали недавно открытый ортонайровирус, опасный для человека. Его назвали вирусом болотистых мест (Wetland virus, или WELV).
Вирус впервые вывили у 61-летнего мужчины в 2019 году. Пациент поступил в больницу с жалобами на лихорадку, головную боль и рвоту. Врачи при осмотре выявили увеличенные лимфатические узлы. Мужчина рассказал, что за пять дней до этого он побывал в болотистом районе Внутренней Монголии, где его покусали клещи.
Исследование показало, что WELV относится к роду ортонайровирусов семейства Nairoviridae. Он наиболее тесно связан с геногруппой переносимых клещами ортонайровирусов Хазарии, куда также входит вирус крымско-конголезской геморрагической лихорадки.
Ученые провели масштабное тестирование среди пациентов с лихорадкой и выявили новый вирус у 17 человек из четырех районов Китая. Они жаловались на лихорадку, головокружение, головную боль, слабость, мышечные боли, артрит и боли в спине. В некоторых случаях возникали петехии (пятна на коже или слизистых оболочках из-за кровотечения из капилляров), локальный отек лимфатических узлов и неврологические симптомы.
В лабораторных анализах отмечалось снижение лейкоцитов и тромбоцитов, а также повышение d-димера (признак образования тромбов) и лактатдегидрогеназы (признак повреждения тканей или органов).
В ходе полевых исследований РНК WELV выявили у пяти видов клещей, а также у овец, лошадей, свиней и забайкальских зокоров (разновидность грызунов), изловленных в северо-восточном Китае. Ученые установили, что клещи передают патоген млекопитающим.
«Улучшение эпиднадзора и выявления новых ортонайровирусов позволит лучше понять влияние, которое эти вирусы оказывают на здоровье человека», – заявили ученые.
Ранее сообщалось, что новый вирус нашли в джунглях Перу. Он опасен для человека.